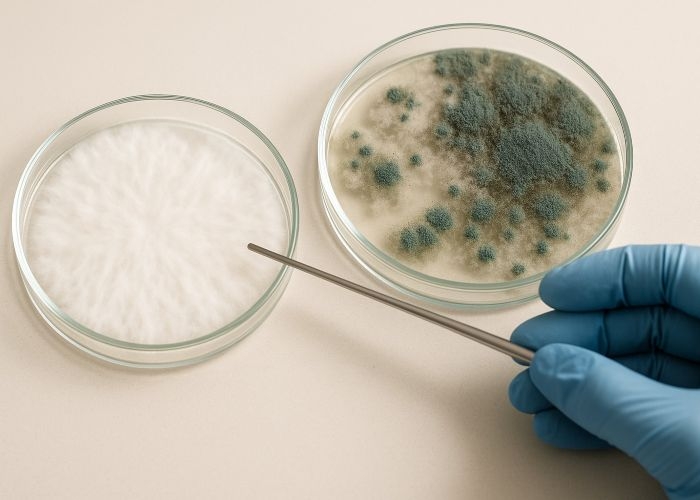

Как триходерма разрушает мицелий: биология в действии
Триходерма — одна из самых устойчивых и агрессивных плесеней, с которой может столкнуться грибовод. Ее поведение в субстрате отличается не только скоростью роста, но и характером воздействия на мицелий: в отличие от большинства контаминантов, она не просто вытесняет конкурента из среды, а активно разрушает его клетки. Этот гриб действует как микроскопический хищник — распознает гифы других видов, охватывает их, проникает внутрь и запускает разрушение клеточной стенки с помощью целого набора ферментов. Результат — гибель мицелия и быстрая колонизация всей массы субстрата.
Такая агрессия сочетается с выдающейся живучестью: споры триходермы переносят засуху, перепады температуры, УФ-облучение, годами сохраняют жизнеспособность в неподходящих условиях. И если заражение все же произошло, борьба с ним на стадии видимых признаков — уже проигранная битва. Чтобы понять, почему эта плесень так опасна и почему при ее появлении остается только утилизация, необходимо рассмотреть ее поведение на уровне клеточной биологии — от споруляции до разрушения мицелия хозяина.
Что делает триходерму микропаразитом
Trichoderma — не просто плесень, а активный биологический агент, способный распознавать, атаковать и разрушать мицелий других грибов. В отличие от типичных сапротрофов, которые питаются мертвой органикой, триходерма предпочитает живые гифы как источник энергии и строительных веществ. Именно это превращает ее в полноценного микопаразита.
Ключ к ее агрессии — развитая система контакта и разрушения. Процесс начинается с химической идентификации: триходерма улавливает сигнальные молекулы, указывающие на присутствие мицелия другого гриба. После этого она направляет к нему свои гифы и разворачивает атаку в несколько стадий:
- Адгезия — гифа триходермы плотно прикрепляется к поверхности клетки “жертвы”, образуя контактную зону.
- Ферментативное разрушение — в месте контакта начинают выделяться хитиназы, β-глюканазы и протеазы. Эти ферменты прицельно разрушают клеточную стенку, состоящую из хитина, полисахаридов и белков.
- Инвазия — после разрушения стенки гифа триходермы внедряется в цитоплазму чужой клетки.
- Ассимиляция — содержимое погибшей клетки (включая аминокислоты, сахара, липиды) усваивается как питательная база.
Это не просто конкуренция за субстрат — это целенаправленное биологическое нападение, при котором один гриб систематически уничтожает другого. Поэтому даже локальное заражение триходермой невозможно «переждать» или «ограничить» — она продолжит атаку до полного вытеснения хозяина.
Как мицелий Psilocybe реагирует на атаку
Мицелий Psilocybe cubensis — это мягкая, уязвимая система, эволюционно не предназначенная для борьбы с агрессивными конкурентами. В отличие от видов, приспособленных к жизни в насыщенной микробной среде (например, лесных сапротрофов), Psilocybe предпочитает субстраты с минимальной конкуренцией: навоз, перегной, плохо заселенные участки почвы. Это делает его идеальной мишенью для микопаразитов вроде триходермы.
С точки зрения клеточной биологии Psilocybe проигрывает по всем направлениям:
- Нет химической защиты. В его метаболоме почти отсутствуют соединения, подавляющие чужеродные ферменты. В то время как триходерма выделяет мощный коктейль из хитиназ и глюканаз, у мицелия Psilocybe нет инструментов, чтобы их нейтрализовать.
- Нет структурной изоляции. Некоторые грибы могут "запечатывать" пораженные участки, отращивать защитные перегородки или формировать барьеры. Psilocybe этого делать не умеет.
- Нет устойчивости к токсинам. Даже если физического контакта еще нет, метаболиты триходермы (низкомолекулярные органические кислоты, вторичные метаболиты) уже изменяют pH среды, тормозят дыхание и синтез белков у Psilocybe.
- Нет стратегий компенсации. Попытки регенерации или отращивания новых гифов неэффективны — скорость роста ниже, чем у триходермы, и все восстановленные участки снова попадают под удар.
Какие ферменты использует триходерма
Агрессивность триходермы — это не случайность, а результат сложной ферментативной стратегии, направленной на разрушение чужого мицелия. Эти ферменты не просто “разъедают” клеточные стенки, а действуют с высокой специфичностью, нацелено и быстро.
- Хитиназы.
Ферменты, разрушающие хитин — ключевой компонент клеточной стенки грибов. Хитиназы работают как “молекулярные ножницы”, расщепляя полисахаридные цепи на фрагменты, после чего стенка теряет прочность. У триходермы представлены несколько классов хитиназ, активных в диапазоне pH от 4 до 7. -
Бета-1,3-глюканазы.
Эти ферменты атакуют бета-глюканы — еще один структурный элемент стенки. Совместно с хитиназами они обеспечивают полный “пролом” в защитной оболочке клетки-жертвы, делая ее доступной для дальнейшего расщепления. -
Протеазы.
После разрушения стенки в ход идут протеазы — они расщепляют белки мембраны, ферменты цитоплазмы и структурные компоненты цитоскелета. В результате клетка теряет осмотическую устойчивость и гибнет. -
Лакказы.
Не все штаммы триходермы их выделяют, но у тех, кто способен — лакказы окисляют фенольные соединения, входящие в состав “химической защиты” некоторых грибов. Таким образом, они обходят барьеры, которые у других плесеней вызывают отторжение. -
Низкомолекулярные метаболиты.
В дополнение к ферментам триходерма выделяет фунгистатические вещества, такие как виридин, харзианол и дерматцидин-подобные соединения. Они:- изменяют pH среды,
- нарушают работу митохондрий и дыхательных цепей,
- ингибируют синтез белка у конкурентов.

Эти вещества особенно опасны на ранних этапах, так как ослабляют рост чужого мицелия еще до прямого контакта. Именно поэтому триходерму невозможно “переждать” — она всегда атакует первой и быстрее.
Механизмы устойчивости и скорости
Trichoderma не просто быстро растет — она приспособлена к выживанию в условиях, губительных для большинства грибов. Эта стойкость объясняется одновременно биохимическими, клеточными и экологическими механизмами.
- Быстрый рост.
Гифы триходермы удлиняются со скоростью до 4–5 мм в час. Это обусловлено высокой митотической активностью в апикальных зонах и наличием плотной сети питательных вакуолей, обеспечивающих локальный прирост массы. Триходерма быстро распространяется как по поверхности, так и в глубину — это делает ее незаметной до появления спор. -
Устойчивость спор.
Споры триходермы (конидии) — ее главное оружие выживания. Они чрезвычайно мелкие, легкие и устойчивые:- К высыханию. Даже полностью обезвоженные конидии могут сохранять жизнеспособность в течение нескольких месяцев.
- К температуре. Кратковременный нагрев до 70–80 °C не разрушает все споры. Если субстрат прогрет неравномерно, часть их выживает.
- К УФ-излучению. Меланизированная оболочка защищает от разрушения ДНК.
- К химии. Некоторые дезинфектанты (например, низкие концентрации перекиси или спирта) не уничтожают споры полностью.
- К pH. Споры и мицелий сохраняют активность в диапазоне pH от 4 до 8, что делает бесполезным изменение кислотности среды в качестве меры защиты.
-
Экологическая гибкость.
Триходерма “умеет” адаптироваться к условиям субстрата: менять тип выделяемых ферментов, изменять рН локально, взаимодействовать с другими микроорганизмами. Это делает ее универсальным захватчиком: она не нуждается в идеально подходящей среде — она ее создает сама. -
Недостатки пастеризации.
Если субстрат слишком влажный или уплотненный, тепло не проникает вглубь. В таких условиях споры триходермы, находящиеся внутри, легко выживают. Особенно часто это случается при использовании кокосового волокна или плохо перемешанного зерна.
Как выглядит разрушение мицелия на практике
Начало заражения триходермой может показаться безобидным. В первые сутки появляется тонкий, белый налет, напоминающий нормальный мицелий Psilocybe. Он может быть чуть более рыхлым, без характерных нитей (ризоморфов), но внешне различия минимальны. Особенно часто заражение начинается возле краев, в зонах с повышенной влажностью или рядом с точками доступа воздуха.
Спустя 24–48 часов налет начинает резко увеличиваться в размере. Влажность усиливает развитие — если есть конденсат или капли воды, триходерма прорастает быстрее. В это же время на субстрате можно заметить:
- потемнение или изменение оттенка нормального мицелия
- разрыхление структуры — вместо плотного мицелия появляется рыхлая масса
- исчезновение блеска или «жизни» в мицелии
- участки, где мицелий как будто расплавился или рассыпался
Это признаки того, что идет активное разрушение клеточных стенок Psilocybe: ферменты триходермы уже начали работу. Даже если визуально поражение кажется локальным, внутри субстрата мицелий гриба уже гибнет.
Через 48–72 часа наступает споруляция. Белый налет становится ярко-зеленым — оттенок может варьироваться от малахитового до темного изумруда. Это значит, что колония зрелая, и споры массово высвобождаются в воздух.

Если зараженный блок не был изолирован до споруляции, начинается аэрозольное загрязнение всей зоны. Споры оседают на другие кейки, поверхности, инструменты и одежду. При этом восстановление зараженного блока невозможно — грибной мицелий уничтожается во всем объеме. Даже если внешне часть блока еще выглядит нормальной, внутри гифы уже деградированы или подавлены.
Почему попытки “спасти” не работают
Идея «удалить заражение» кажется логичной — если видно зеленое пятно, почему бы просто не срезать его или не обработать? Проблема в том, что к моменту появления видимых признаков триходерма уже распространилась вглубь субстрата. Ее гифы пронизывают массу, а ферменты и токсины начинают действовать еще до споруляции.
Удаление верхнего слоя не уничтожает гифы, уже внедренные в нижние слои. Даже если срезать или выскрести пораженную часть, внутри остаются активные колонии, которые продолжат рост. Попытки обработать поверхность химикатами дают кратковременный эффект:
- Соль может ингибировать развитие на поверхности, но она не убивает гифы, уже распространившиеся вглубь. Более того, соль нарушает осмотический баланс и сама по себе может повредить мицелий Psilocybe.
- Гипс способен немного сдвинуть pH среды, делая ее менее комфортной для триходермы, но не оказывает фунгицидного действия и не затрагивает грибницу в глубине.
- Перекись водорода эффективна только на поверхности — она дезактивирует споры и уничтожает часть наружных клеток, но не проникает внутрь субстрата и не затрагивает зону, где активен мицелий паразита.
Кроме того, триходерма демонстрирует высокую способность к восстановлению. Даже если ее рост приостановлен на 12–24 часа, при наличии влаги и субстрата она возобновляет активность. Все случаи «частичного лечения» приводят к одному:
- ухудшение структуры субстрата
- отсутствие полноценного плодоношения
- повторное проявление заражения
- распространение спор по всему боксу или помещению
Поэтому кейки, на которых была замечена триходерма, особенно после появления зеленого налета, подлежат утилизации. Попытки их «спасти» чаще всего оборачиваются потерей всего цикла.
Подход к профилактике
Чтобы остановить триходерму, нужно не бороться с последствиями, а не допускать самого заражения. Вся логика профилактики строится на понимании ключевого принципа: точка входа должна быть точкой контроля. Это значит, что каждый этап, на котором возможен контакт со спорами, должен быть перекрыт заранее.
- Термическая обработка
Самый надежный способ обезвредить споры — стерилизация. Автоклав или скороварка при 121°C минимум 90 минут полностью разрушают споры, ферменты и белковые структуры. Особенно это важно для зерновых субстратов. Пастеризация — лишь условная мера: при неправильной плотности или влажности она может не задеть внутренние слои. -
Асептическая работа
Все, что контактирует с субстратом, должно быть либо одноразовым, либо прошедшим термическую или химическую обработку. Шприцы, фильтры, крышки, банки — все обрабатывается спиртом или автоклавируется. Ламинарный бокс — идеал. В его отсутствие допустимо работать над горелкой или свечой с минимизацией времени контакта воздуха и среды. -
Чистота воздуха
HEPA-фильтрация воздуха в рабочей зоне — лучшая защита. При ее отсутствии инокуляция проводится в статичной атмосфере: выключается вентиляция, окна закрыты, движение сведено к минимуму. Любая пыль может содержать споры — значит, вся она должна быть устранена заранее. -
Разделение стадий
Инокуляция и плодоношение — это две разные фазы с разным уровнем риска. Первая требует стерильности, вторая — стабильности. Разделение по времени и помещению исключает перекрестное заражение. Инструменты и поверхность не должны перемещаться между зонами без обработки. -
Контроль параметров субстрата
Плотный и влажный субстрат хуже прогревается, медленнее остывает и создает внутри анаэробные зоны — идеальные для спор. Оптимально:- влажность — не выше 65%
- структура — равномерная, без комков
- температура при обработке — должна достигать всех участков
Профилактика требует рутинной, четкой и дисциплинированной работы. Но в долгосрочной перспективе именно это экономит время, урожай и нервы.
Источники:
- Fungi Academy. Mushroom contamination: How to spot and what to do.
- Grow Magik. Trichoderma in monotub mushroom growing.
- Alchimia Grow Shop. Contamination in magic mushroom cakes, what to do and how to prevent it?